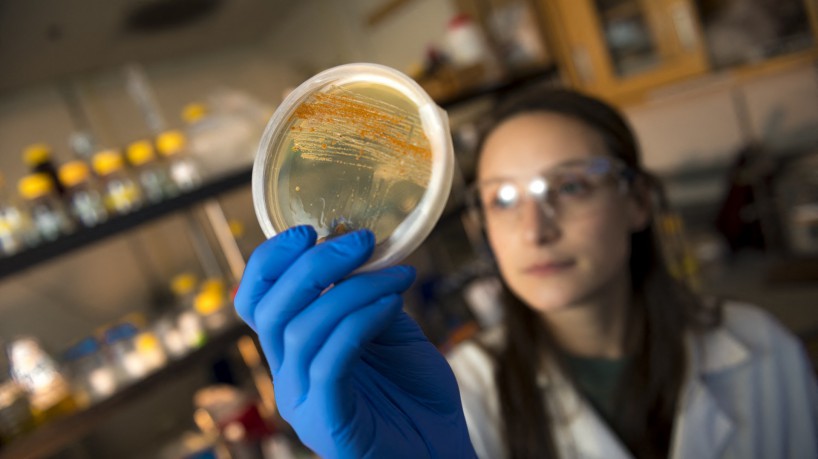
Os pesquisadores coletam sedimentos do fundo do oceano e cultivam os micróbios que encontram no laboratório. Mais de uma década de trabalho rendeu duas drogas anticancerígenas, uma para câncer de pulmão e outra para o intratável tumor cerebral glioblastoma. Ambos estão em fase final de ensaios clínicos
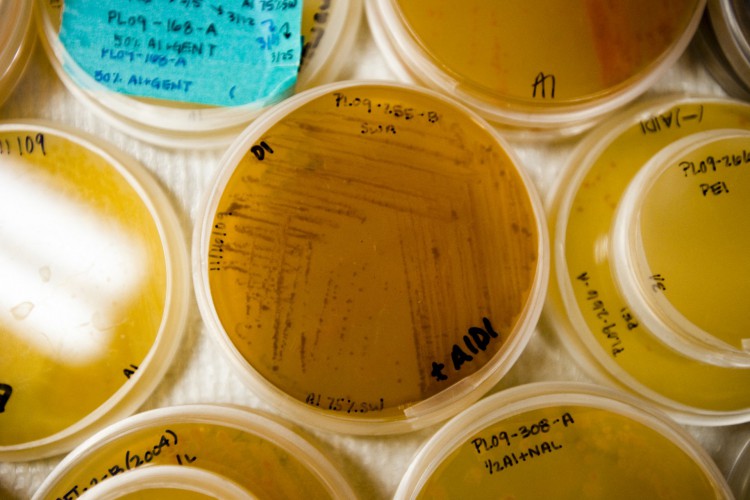
Esta fotografia sem data divulgada pelo Scripps Institution of Oceanography na UC San Diego mostra amostras marinhas sendo preparadas para estudo no laboratório de William Fenical, Scripps Institution of Oceanography, em San Diego

Pesquisas médicas buscam no fundo do mar as moléculas do futuro
Uma molécula medicinal pode ser encontrada em esponjas porosas, criaturas com corpo de barril que se agarram a rochas ou à parte inferior de barcos ou por bactérias que vivem simbioticamente em um caracol
Cientistas procuram nos micróbios de sedimentos marinhos, nas bactérias que vivem em simbiose com um molusco ou ocultas nas secreções de uma esponja, moléculas capazes de conduzi-los a um tratamento revolucionário contra o câncer ou à fabricação de um novo antibiótico.
As amostras coletadas no fundo dos oceanos às vezes consistem simplesmente em uma pequena quantidade de lama colocada em um tubo, mas a falta de orçamento e o escasso apoio dos laboratórios obrigam os pesquisadores a contar com expedições externas e muita imaginação para obtê-las.
É + que streaming. É arte, cultura e história.
É apenas o primeiro passo. Quando uma molécula finalmente revela seus benefícios - por exemplo, para o mal de Alzheimer ou a epilepsia - ainda são necessárias décadas e centenas de milhões de dólares para transformá-la em um medicamento.
Esta fotografia sem data divulgada pelo Scripps Institution of Oceanography na UC San Diego mostra amostras marinhas sendo preparadas para estudo no laboratório de William Fenical, Scripps Institution of Oceanography, em San Diego
As negociações das Nações Unidas no início de março sobre um tratado para proteger o alto-mar colocaram essas investigações sob os holofotes buscaram um acordo sobre as zonas marítimas protegidas.
Os estados disputam a divisão dos benefícios dos recursos genéticos marinhos, como os que são usados em remédios, bioplásticos ou aditivos alimentares, explica Daniel Kachelriess, colíder das negociações para a High Seas Alliance, uma coalizão de ONGs.
No entanto, só uma pequena quantidade de produtos provenientes de recursos genéticos marinhos chega ao mercado. Em 2019, foram apenas sete, aponta Kachelriess.
Os potenciais direitos de licença são estimados entre 10 e 30 milhões de dólares por ano. Provavelmente há muito mais para descobrir na diversidade biológica dos oceanos.
Luta contra o câncer
"Quanto mais procuramos, mais encontramos", diz Marcel Jaspars, da Universidade de Aberdeen, na Escócia.

Esta fotografia sem data divulgada pelo Scripps Institution of Oceanography na UC San Diego, mostra o professor de oceanografia do Scripps Institution of Oceanography e diretor do Scripps Center for Marine Biotechnology and Biomedicine, William Fenical, com um instrumento de coleta de sedimentos, em San Diego
Em 1928, o cientista Alexander Fleming descobriu um fungo que produzia uma substância que matava bactérias, a penicilina. Desde então, cientistas seguiram encontrando moléculas com poder de cura em plantas, animais, insetos e micróbios. Tudo na superfície terrestre.
"A grande maioria dos antibióticos e medicamentos contra o câncer vem de fontes naturais", lembra William Fenical, professor do Instituto de Oceanografia Scripps, na Califórnia.
Esse pioneiro de 81 anos começou a investigar moléculas marinhas em 1973, numa época cheia de ceticismo sobre a possibilidade de encontrar produtos valiosos no fundo do mar.
Mas na década de 1980 ele e sua equipe encontraram um coral mole nas ilhas das Bahamas que produzia uma molécula anti-inflamatória. Mais tarde, ela seria utilizada em produtos cosméticos da marca Estée Lauder.
Em 1991, também nas Bahamas, pesquisadores identificaram uma bactéria desconhecida, a Salinispora, que deu origem a dois medicamentos contra o câncer, atualmente em fase final de testes clínicos.

Esta fotografia sem data divulgada pelo Scripps Institution of Oceanography na UC San Diego mostra uma visão microscópica de Salinispora tropica, um organismo marinho com potencial para tratar doenças como o câncer
Ascídias
Carmen Cuevas Marchante, chefe de pesquisa da PharmaMar, uma empresa espanhola de biotecnologia, está acostumada com esse longo processo.
Para elaborar seu primeiro remédio, a farmacêutica precisou primeiro coletar 300 toneladas de ascídias bulbosas, uma espécie de invertebrado cilíndrico que se agarra a pedras ou embaixo de barcos.
"Foi preciso uma tonelada para isolar menos de um grama" da molécula necessária para os ensaios, disse Cuevas Marchante à AFP. Com isso, a empresa conseguiu criar três medicamentos contra o câncer e aperfeiçoou seus métodos de síntese.
Desde 1969, 17 medicamentos de origem marinha foram autorizados para o tratamento de doenças. Além disso, cerca de 40 estão em fase de ensaios clínicos, de acordo com o site Marine Drug Pipeline.
Segundo especialistas, esse baixo número se explica pelo enorme custo dos testes - às vezes superiores a 1 bilhão de dólares (5,2 bilhões de reais) -, o que favorece o desenvolvimento de medicamentos mais caros.
A maioria desses fármacos ajuda a tratar o câncer, mas também há um antiviral contra a herpes que veio de uma esponja do mar e um analgésico oriundo de um caracol.
A molécula do próximo antibiótico ou tratamento para o HIV pode estar escondida em uma criatura no fundo do oceano. A menos que já esteja em nosso poder, nas vastas bibliotecas de moléculas que faltam ser testadas.
Dúvidas, Críticas e Sugestões? Fale com a gente
